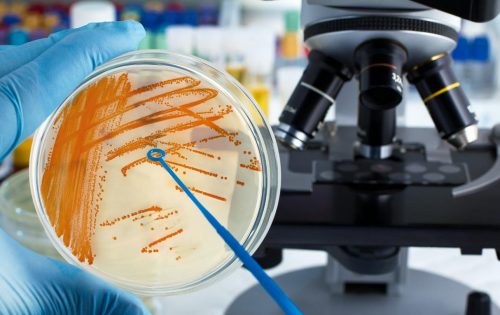

Confirman el quinto muerto por Estreptococo
Un hombre de 40 años murió en las últimas horas por la bacteria estreptococo (streptococcus pyogenes) y ya son 5 las muertes en el país por esta causa.
Se trata de Nicolás Dominé, un hombre que vivía en Pergamino e ingresó el domingo a un sanatorio privado por una insuficiencia respiratoria grave y murió el lunes, según confirmó la secretaria de Salud, María Marta Perreta.
El estreptococo es la angina bacteriana que generalmente empieza con síntomas de una angina o con una fiebre sin motivo.
Comentarios

